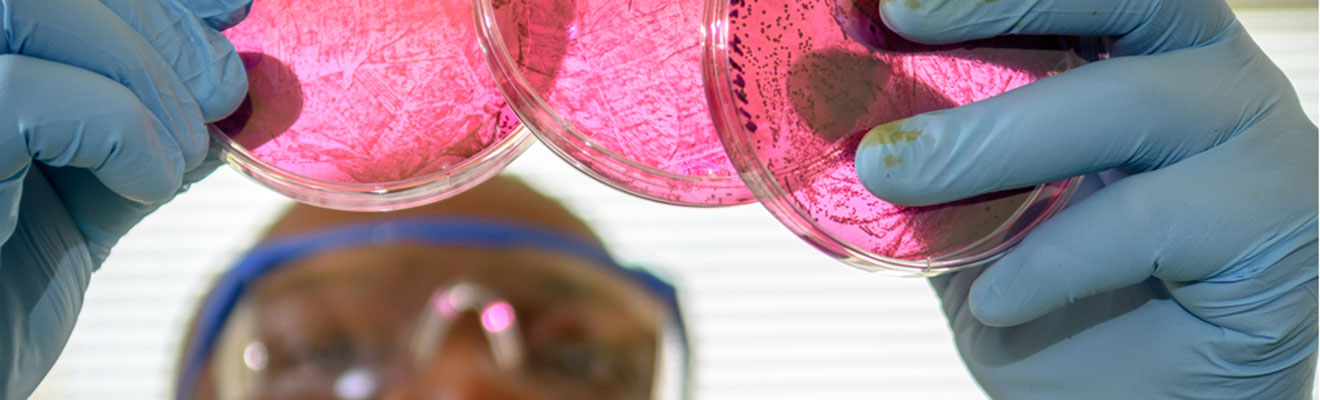
A male student in lab environment is examining some brightly colored petri dishes. He is wearing protective goggles and gloves

A little competition fires up high school students, especially when it lets them build something that helps the environment.
With help from 3D printers and graduate students at UNC Greensboro and North Carolina Agricultural and Technical State University, one such competition capped off a week of problem-based learning, centered around an element found in everything from DNA to matches to fertilizer.
The 17 students took part in ExPlorers, a summer camp run by the Joint School of Nanoscience and Nanoengineering (JSNN). ExPlorers takes scientific and engineering concepts that demand long hours of lab work and study for PhD students and faculty and makes them relatable to high school students, helping them see how science connects everything they interact with day-to-day.
“Every time I come to the camp, I get to learn a little more about different aspects of STEM,” says Mackenzie “Mac” Alexander, a Grimsley High School student back for her third year with ExPlorers. “It has biochemical, mechanical, industrial, and civil engineering.”
The camp challenges the participants to get creative with their newfound knowledge, then bring it back home. “The students are now able to say A, B, or C about phosphorus sustainability to someone on the street,” says Raphael Ayivi, a UNCG student working on his PhD in nanoscience “That’s what we are trying to do: help them get that message out and develop their interest in science.”
Everyday Experience Brought Down to Scale
ExPlorers is part of STEPS, or “Science and Technologies for Phosphorus Sustainability.” Funded by the National Science Foundation, this collaboration between ten universities and research institutions aims to decrease the world’s dependability on mined phosphorus.
North Carolina, with Florida, accounts for 75 percent of the United States’ phosphorus output. The world currently has stored enough phosphorus to last 50 years. While phosphorus is critical in many industries, particularly food production, its byproducts often end up in waterways due to runoff and contribute to dangerous algae blooms that devastate ecosystems.
Most mined phosphorus is used in agriculture, so the students also took a field trip to NC A&T’s farm. Poultry Research Specialist Mark Paylor led the tour. He brought first-hand experience of the challenges farmers deal with to raise healthy livestock and grow crops that eventually end up on the students’ dinner tables.
“Taking them to the farm to see where a majority of phosphorus is used and how it is introduced into a lot of those systems is impactful,” says Dr. Zelena Johnson ’24, a camp organizer who earned her PhD in nanoscience from UNCG. “They may wonder, ‘Why should we care? I don’t use phosphorus.’ But they do. The food they eat is grown with phosphorus. The protein they get is from animals that have consumed plants grown by phosphorus.”
“I get upset about how much waste is produced every day,” says Eliza “EC” Resuello from the Middle College at Forsyth Tech. “Hopefully, we can help study how to limit how much goes into the environment, and then see how we can slowly start to recover over the years.”
JSNN – a School that knows all about working with materials too small to see with the naked eye – put together interactive lab stations so that students could relate nanoscience and nanoengineering to their various interests and hobbies back home. Poshika Prabu, a rising tenth grader from Triangle Math and Science Academy, says one of her favorite activities was making poppings that go into boba tea. This taught her an engineering method called polymer cross-linking.
“My parents are always saying, ‘Why do you like boba?’ It’s because you can pop it in your mouth,” says Prabu. “I got to see how the membrane was enclosed and how the liquid was put inside.”
The lab activities were a plus for Elijah Dorsey from Weaver Academy. “I was expecting boring lectures for most of the week and then something fun at the end at the farm. But it’s all been interesting. We can talk freely with other classmates, working together, collaborating, and learning.”
“Sometimes in science, we have a hard time communicating these issues to lay people,” says Johnson. “The easiest people to communicate with are these students. They’re still learning about life and what’s out there. If we catch them early, they’re able to communicate with their peers and their families.”
Science Made Tangible with Sensors
All the experiences that week culminated in an interactive project with real-world implications. The students were assigned to small groups led by a graduate student to develop a sensor for improving phosphorus sustainability. They had to treat it as a potential resource for the future, considering how it impacts people, the environment, and how much it might cost.
“If you’re going into a business in anything, even scientific research, it’s all about the dollar bill,” says Johnson. “We have to pay for the research, the researchers, and the material. They also have to ask, is it sustainable? Will their product last generations? If their idea would negatively impact the environment, then it’s not an idea they want to follow.”
Resuello put her artistic skills to use in her group, designing a freshwater-friendly device that could be filled with sensors and filters. “I wasn’t expecting that I would be doing 3D modeling here,” says Resuello. “I have never done that before. And I’m happy that my model turned out not too bad. That’s one of the skills that I acquired.”
Each group created a 3D-printed prototype, and on the last day, they presented it in a “Shark Tank”-style pitch. Their families were invited to attend their presentations, further giving the students a sense of ownership for what they had learned.



Grads Build a Pathway for Knowledge
The camp’s message was made more effective by the leadership of graduate students from UNCG and NC A&T. This was an intentional choice by JSNN.
Ayivi has worked with ExPlorers since 2022. The camp meshes with his own research developing a molecularly impressive sensor for detecting phosphorus pesticides.
“It brings joy to me because I’m passionate about knowledge transfer,” says Ayivi. “Some young people don’t have people to make science fascinating to them. But if they can encounter it and interact with people, that makes science very friendly, very fun, and very informative.”
The graduate students also demonstrated to the camp participants how scientific discoveries are passed along: from student to student, from student to parents, then from parents to the community.
“Working with the grad students, there’s a connection there,” says Dorsey. “They’re younger. They’re in the field, so they know what’s currently happening. They know how to connect with professors.”
The students left the camp with much more than a 3D-printed prototype. They took home a new appreciation for how they enact change, as well as renewed confidence in exploring future careers in science.
Prabu made an hour-long drive from Apex to attend ExPlorers each day, and she says it was worth it. “I learned at this camp that phosphorus is really important, and I want to convey that to my parents and loved ones,” she says. “I can tell my parents to look at what they’re eating. That food has phosphorus in it. Your DNA has a phosphate backbone.”
“If you’re undecided about what you want to do for college, this camp is a good place to come,” says Alexander. “It doesn’t just focus on one aspect of STEM. It’s not just science. It’s not just chemistry. It’s not just technology. It focuses on everything.”
Story by Janet Imrick, University Communications
Photography by Sean Norona, University Communications
Video by Sean Norona and David Lee Row, University Communications
Video editing by David Lee Row, University Communications